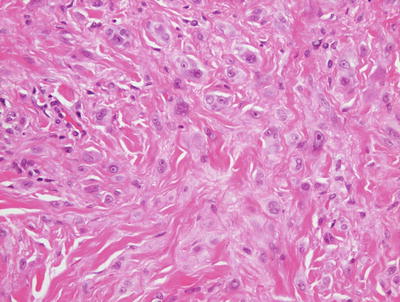
A324456_1_En_20_Fig35_HTML.jpg
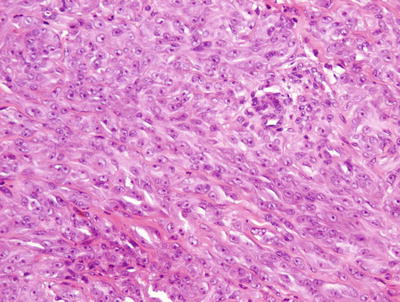
A324456_1_En_20_Fig41_HTML.jpg

, Teresa S. Wright2, Crystal Y. Pourciau3 and Bruce R. Smoller4
(1)
Department of Pathology & Immunology, Baylor College of Medicine and Texas Children’s Hospital, Houston, Texas, USA
(2)
Departments of Dermatology and Pediatrics, University of Tennessee Health Science Center, Memphis, TN, USA
(3)
Departments of Dermatology and Pediatrics, Baylor College of Medicine and Texas Children’s Hospital, Houston, Texas, USA
(4)
Department of Pathology and Laboratory Medicine, University of Rochester School of Medicine and Dentistry, Rochester, NY, USA
20.1 Lentigines/Lentigo Simplex
20.1.1 Clinical Features
Lentigines (lentigo simplex) are small (typically <5 mm), tan to brown-black macules that can develop on any cutaneous surface, including mucous membranes and palmoplantar skin. They may be present at birth or may appear during childhood, and often increase in number well into adulthood. They can be single or multiple as well as disseminated, clustered, or segmental. Lentigines do not have a predilection for sun-exposed areas, and they do not darken with sun exposure. Occasionally, they are associated with multisystem genetic disorders. The frequency of lentigines in children is unknown. They affect all races and both sexes equally [1].
20.1.2 Histology
Lentigo simplex is characterized by orthokeratotic keratin overlying an epidermis with elongated rete ridges. There is increased melanin within basilar keratinocytes (Fig. 20.1). Melanocytes are minimally increased in number, and they are not atypical [2]. There is no nesting of melanocytes as seen in a junctional nevus. The dermis is unremarkable. Specifically, it is distinctly unusual for a lentigo simplex to induce a significant inflammatory response or upper dermal fibrosis. The presence of such changes warrants careful examination to exclude histologic mimics.


Fig. 20.1
Lentigo simplex has elongated rete ridges and increased basilar melanin . There are essentially normal numbers of melanocytes present in the epidermis. Sun damage is not present in the underlying dermis
The differential diagnosis of lentigo simplex includes melanocytic nevus with or without features of atypia. In many cases, examination of multiple levels reveals small intraepidermal nests of melanocytes. Most dermatopathologists make the arbitrary distinction that nests of melanocytes establish a diagnosis of a melanocytic nevus, and exclude the diagnosis of a lentigo simplex. The presence of a lymphoid infiltrate within the papillary dermis with or without accompanying fibrosis should provoke additional search for changes of a dysplastic nevus because these features are not part of the constellation of findings associated with lentigo simplex. The differential diagnosis also includes café au lait macules . In this case, histologic distinction may be impossible. While macromelanosomes are often associated with café au lait macules, similar observations have been described in lentigo simplex, and their presence does not exclude either diagnosis [3].
20.1.3 Pathogenesis
Mutations in the growth regulatory factors BRAF, FGFR3, and PIK3CA are frequently found in melanocytic nevi. Studies examining the presence of these gene mutations in 58 lentigo simplex and 46 melanocytic nevi showed that lentigo simplex did not harbor BRAF, FGFR3, or PIK3CA mutations [2]. In contrast, melanocytic nevi had frequent BRAF V600E mutation. It has been suggested that the absence of BRAF, FGFR3, and PIK3CA mutations differentiates lentigo simplex from solar lentigo and melanocytic nevi. These findings indicate that lentigo simplex has a distinct yet unknown genetic basis from that of solar lentigo and nevi. Other genes have been identified in association with lentigo simplex. The development of lentigines in German and Japanese women has been shown to correlate with variants in the SLC45A2 gene [4]. In addition, a somatic mutation in KRT10 gene is associated with extensive lentigo simplex, linear epidermolytic nevus, and epidermolytic nevus comedonicus [5].
20.2 Labial Melanotic Macule
20.2.1 Clinical Features
Labial melanotic macules are brown, gray, or blue spots on the oral mucosa. They are usually solitary. Most lesions are less than 1 cm in diameter, although they are occasionally larger [6]. They are most common in adults over 40 years of age, but have been reported in children >4 years of age. They appear to be somewhat more common in females than in males [7].
20.2.2 Histology
Labial melanotic macule demonstrates a mucosa that has increased basal layer melanin without increased numbers of melanocytes (Fig. 20.2). Many of the intralesional melanocytes may have a dendritic configuration. Dermal melanin secondary to pigment incontinence is often present. The changes are essentially those of a lentigo simplex occurring on a mucosal surface [8, 9]. Melanocytes have densely pigmented melanosomes [10].


Fig. 20.2
A labial melanotic macule demonstrates a mucosal surface with increased basilar melanin in the absence of increased numbers of basilar melanocytes
20.2.3 Pathogenesis
The cause of labial melanotic macule is not known. It is thought to be a reactive process and related to sun exposure [7]. It has been proposed that hyperpigmentation in the epidermal basal layer as well as the presence of dermal melanophages may be due to faulty transfer of melanosomes from melanocytes to keratinocytes, resulting in a lack of melanosomes in keratinocytes in the upper epidermis and pigment incontinence in the dermis.
20.3 Ephelis
20.3.1 Clinical Features
Ephelides (freckles) are small (<3 mm) light-brown macules that occur mainly on sun-exposed areas in individuals with fair skin and red hair. Ephelides typically appear during childhood (especially between 2 and 4 years of age), and tend to fade by adulthood. They darken with sun exposure, and fade in the winter. Ephelides do not undergo malignant transformation, but they are considered to be a sign of UV-induced skin damage, and their presence correlates with an increased lifetime risk of malignant melanoma [11].
20.3.2 Histology
Ephelis is histologically quite similar to lentigo simplex, differing only in a slightly fewer number of basilar melanocytes (Fig. 20.3). Ephelis is characterized by increased amounts of basilar melanin within keratinocytes, and normal to slightly increased numbers of melanocytes [12]. Pigment incontinence may be present within the papillary dermis.


Fig. 20.3
An ephelis demonstrates increased basilar melanin within keratinocytes and only a minimal increase in melanocytes
The histologic differential diagnosis of an ephelis includes a lentigo simplex. Another entity that should be considered is café au lait macule that is distinguished based upon the clinical appearance.
20.3.3 Pathogenesis
Ephelides are commonly associated with light skin and blond or red hair color, and are generally considered to be genetically determined. The melanocortin-1-receptor (MC1R) gene is strongly associated with the formation of ephelides [11, 13, 14]. Other genes, including IRF4, ASIP, OCA2, and tyrosinase, are also associated with ephelides [15–17]. Exposure to sunlight accentuates the pattern of ephelides. It has been shown that ultraviolet light interacts with MC1R and OCA2 variants to enhance facial ephelides in children [18].
20.4 Becker’s Nevus
20.4.1 Clinical Features
Becker’s nevus appears as a localized area of hypermelanosis and often hypertrichosis, most common on the chest, shoulder, and upper back of an adolescent male. It has been reported on other areas of the body, including the face, trunk, arms, and legs. Becker’s nevus is sometimes congenital, but it usually appears in adolescence. Rarely, it affects younger children. It is more common in males than females. Although Becker’s nevus is usually an isolated finding, associated abnormalities are occasionally seen (e.g., ipsilateral breast hypoplasia and limb asymmetry) [19]. Typically, a unilateral blotchy, grayish-brown patch appears over the chest, shoulder, and upper back (Fig. 20.4). Terminal hairs often develop within the lesion.


Fig. 20.4
Becker’s nevus presents as a well-demarcated hyperpigmented patch with overlying hypertrichosis at the lower torso in a teenage boy (photo courtesy of Audrey Chan, MD, Baylor College of Medicine, Houston, TX)
20.4.2 Histology
This hamartomatous process involves changes within the epidermis and dermis. The epidermis is occasionally papillomatous with slight epidermal acanthosis and elongation of the rete ridges (Fig. 20.5). The basal layer demonstrates increased melanin pigment within keratinocytes, but only a slight increase in the number of melanocytes [20]. Occasional giant melanosomes may be seen, but these are not a specific finding [21]. The changes within the epidermis may resemble those seen in a lentigo simplex. Multiple large hair follicles are present in many cases. The underlying dermis often contains a smooth muscle hamartoma, but this is not a universal finding [22].


Fig. 20.5
A Becker’s nevus is characterized by a slightly acanthotic epidermis that may be papillomatous . The basal layer has increased melanin with only minimally increased number of melanocytes. Abundant large smooth muscle bundles are present in the dermis
The histologic differential diagnosis includes lentigo simplex, which is differentiated based upon clinical presentation. A nevus spilus has intraepidermal changes that resemble Becker’s nevus, but it also has foci with nests of melanocytes that help to make the distinction. The smooth muscle proliferation within the dermis raises the differential diagnosis of leiomyoma. The nodular configuration of smooth muscle fascicles helps make the diagnosis of leiomyoma.
20.4.3 Pathogenesis
Becker’s nevus is a benign hamartomatous proliferation. It has been hypothesized that during embryogenesis, somatic gene mutations can occur in healthy heterozygote individuals resulting in loss of heterozygosity (LOH) where the hamartomatous area presumably originates [23]. There is some evidence that Becker’s nevus is a hormone-dependent disorder caused by dysregulation of androgen receptor activity [24]. Congenital and familial cases have been reported, and suggest a hereditary component in the etiology of this lesion [25].
20.5 Café Au Lait Macule
20.5.1 Clinical Features
Café au lait macules are well defined oval to round, light-brown macules or patches. They are present at birth or in early childhood, and can appear anywhere on the body. They may range in size from approximately 1 cm up to 20 cm in diameter (Fig. 20.6). Café au lait macules are often an isolated finding, but they may also be a sign of neurofibromatosis or other systemic disorders. Café au lait spots are present in up to 33 % of children [26].


Fig. 20.6
Café au lait macules appear as well-defined tan macules and patches
20.5.2 Histology
Histologic changes seen in café au lait macules are subtle and nonspecific. The epidermis generally has normal thickness with no changes in the stratum corneum. There is increased basilar melanin pigment without increased number of melanocytes. Macromelanosomes have been reported in these lesions, and they are said to occur with increased frequency in lesions from patients with neurofibromatosis type 1 [27, 28]. Pigment incontinence may result in the presence of melanophages within the papillary dermis.
20.5.3 Pathogenesis
Café au lait macules in children are common dermatologic findings that can arise in a variety of disease conditions, such as neurofibromatosis type 1 and certain types of hereditary syndromes , such as McCune-Albright, Cowden, LEOPARD, and Bannayan-Riley-Ruvalcaba syndromes [29]. The pathogenesis of these lesions can be found under the specific disease syndrome.
20.6 McCune-Albright Syndrome
20.6.1 Clinical Features
McCune-Albright syndrome is a condition characterized by the classic triad of café au lait spots, polyostotic fibrous dysplasia, and endocrine dysfunction (e.g., precocious puberty). In comparison to the lesions seen in neurofibromatosis, café au lait spots of McCune-Albright syndrome tend to be fewer in number, larger, and darker. They are typically unilateral, often with sharp demarcation at the midline (Fig. 20.7). They also have more jagged margins that are classically described as a “coast of Maine” appearance [30].


Fig. 20.7
A child with McCune-Albright syndrome presents with a large, sharply defined tan patch with jagged border
20.6.2 Histology
The most common cutaneous manifestation in patients with McCune-Albright syndrome is that of pigmented lesions that are clinically and histologically indistinguishable from café au lait macules. There is increased basilar melanin within basal keratinocytes and melanocytes. Some cases may contain macromelanosomes [31].
Melanocytic nevi with intranuclear pseudoinclusions [32] and diffuse scarring alopecia with fibrous convolutions [33] have been described with histologic changes that may be relatively unique to McCune-Albright syndrome. There are other cutaneous lesions that have been biopsied in patients with the syndrome. These include oral pigmented lesions, osteoma, calcifying aponeurotic fibroma-like lesions, and calcinosis cutis [32, 34, 35].
20.6.3 Pathogenesis
McCune-Albright syndrome is caused by mutations in GNAS1, which encodes the G-protein subunit Gsα [36, 37]. Conversion of Arg201 to histidine or cysteine is a frequent mutation in GNAS1. Mechanistically, mutations in GNAS1 lead to constitutive activation of GNAS1 and the coupled protein adenylyl cyclase, resulting in an increase in intracellular cyclic adenosine monophosphate (cAMP) levels [38, 39]. Activation of G-protein-coupled receptors, such as luteinizing hormone and follicle-stimulating hormone receptors, may be the molecular underpinning of the signs and symptoms of the syndrome. The formation of brown/black pigments is normally stimulated by melanocyte-stimulating hormone (MSH) binding to MSH receptor, which is a G-protein receptor coupled to Gsα. Constitutive activation of the Gsα subunit in melanocytes results in increased brown pigmentation characteristic of autonomous endocrine hyperfunction and café au lait spots seen in McCune-Albright syndrome [40, 41]. There are sporadic somatic mutations in one of the two alleles of GNAS1 gene with mosaicism, in which the severity and specific features of the disorder depend on the number and location of cells that have mutated GNAS1. There is no autosomal dominant transmission of this syndrome because activating GNAS1 mutations are lethal when they occur early in embryogenesis [42].
20.7 Peutz-Jeghers Syndrome
20.7.1 Clinical Features
Peutz-Jeghers syndrome is an autosomal dominant disorder characterized by multiple mucocutaneous lentigines and hamartomatous intestinal polyps. Lentigines of Peutz-Jeghers syndrome are small (<5 mm) bluish brown to black spots that are present at birth or develop in early childhood (Fig. 20.8). They tend to affect the lips and buccal mucosa, nasal and periorbital skin, elbows, dorsal fingers and toes, palms and soles, and periumbilical, perianal and labial skin. Lesions on the lips and skin may fade after puberty.


Fig. 20.8
Multiple brown macules are seen on the lips of a patient with Peutz-Jeghers syndrome
20.7.2 Histology
The predominant cutaneous lesions are simple lentigines that are histologically indistinguishable from lentigo simplex. These pigmented lesions occur on the skin, and in and around the oral cavity. Those occurring on mucosal surfaces demonstrate the histologic changes of labial melanotic macules [43, 44]. Prominent palmoplantar pigmentation with lentigo simplex-like histology on acral skin is also described in these patients [45, 46]. An interesting phenomenon is the late onset of lentigines occurring at the sites of psoriatic plaques in Peutz-Jeghers syndrome [45]. In any of the aforementioned situations, the histologic changes are nonspecific, and result in the histologic diagnosis of lentigo simplex. Clinicopathologic correlation is required to establish a diagnosis of Peutz-Jeghers syndrome.Sebaceous lesions including sebaceous adenomas and sebaceomas, which are more commonly encountered as cutaneous tumors associated with Muir-Torre syndrome, have been described in patients with Peutz-Jeghers syndrome [44].
20.7.3 Pathogenesis
Peutz-Jeghers syndrome is a cancer-susceptibility syndrome that is due to inactivating germline mutations in STK11/LKB1 gene on chromosome 19p [47, 48]. Some studies demonstrate a detection rate of germline mutations in STK11/LKB1 to be between 80 and 94 % of the cases [49]. However, other studies have shown that LKB1 mutations account for only 40–60 % of familial cases of Peutz-Jeghers syndrome [50]. STK11/LKB1 is expressed ubiquitously in fetal and adult tissues. It is a tumor suppressor with serine-threonine protein kinase activity [51]. A major function of STK11/LKB1 is to control the metabolism and energy homeostasis in the cell by regulating AMP-activated protein kinase (AMPK) cascade [52, 53]. STK11/LKB1 has multiple other important functions, including the regulation of cell proliferation via G1 cell-cycle arrest. STK11/LKB1 mutations affect the phosphorylation of β-catenin and regulation of WNT signaling [54]. LKB1 also associates with p53 and regulates p53-dependent apoptotic pathways [55].
20.8 Congenital Dermal Melanocytosis (Mongolian Spot)
20.8.1 Clinical Features
Congenital dermal melanocytosis (Mongolian spot) is present in about 96 % of black infants, 46 % of Hispanic infants, and 10 % of white infants [56]. Skin lesions are deep brown to slate gray or blue-black patches that are present at birth (Fig. 20.9). They are most common at the lumbosacral area and buttocks , but can occur in other locations. Mongolian spots may be single or multiple, and range in size from a few mm to several cm or more. Many tend to fade during the first few years of life, although a small percentage can be more persistent. Affected infants are usually healthy. Congenital dermal melanocytosis can occur sporadically or, in cases of extensive and large lesions, can be associated with inborn errors of metabolism, such as mucopolysaccharidosis, gangliosidosis, Niemann-Pick disease, Hunter syndrome, and mannosidosis [59–63]. Lesions can also be associated with other pigmentary abnormalities, such as phacomatosis pigmentovascularis [64].


Fig. 20.9
Congenital dermal melanocytosis appears as a faint blue patch over the lumbosacral area (photo courtesy of Minh Hoang, MD, Ho Chi Minh City, Vietnam)
20.8.2 Histology
Skin lesion is characterized by a normal dermis. Within the mid- to deep reticular dermis, there is a fairly sparse collection of densely pigmented dendritic melanocytes that often display a horizontal orientation (Figs. 20.10 and 20.11). These pigmented cells may extend into the subcutis [57, 58].



Fig. 20.10
Histologic changes in congenital dermal melanocytosis consist of scattered hyperpigmented spindle-shaped cells deep in the reticular dermis

Fig. 20.11
Spindle-shaped and dendritic melanocytes are seen in the deep dermis in congenital dermal melanocytosis. There is no cytologic atypia
The histologic differential diagnosis includes other entities characterized by densely pigmented dendritic melanocytes in the dermis. Nevus of Ota and nevus of Ito have similar histologic features to congenital dermal melanocytosis, but these two entities (with identical histologic features) are more densely cellular, and the melanocytes are located higher within the dermis. A blue nevus also has similar histologic features; however, there is far more pigment and dense cellularity in blue nevi.
20.8.3 Pathogenesis
Congenital dermal melanocytosis is thought to be due to the failure of migration of melanocytes from the neural crest to the epidermis during fetal life, resulting in the presence of melanocytes in the dermis.
20.9 Nevus Spilus (Speckled Lentiginous Nevus)
20.9.1 Clinical Features
Speckled lentiginous nevus or nevus spilus is a pigmented lesion composed of a tan patch with multiple small, darkly pigmented macules and papules superimposed within it (Fig. 20.12). It affects 1–2 % of the population [65]. It is most common on the trunk and extremities. The background tan patch is rarely present at birth, but usually appears within the first year of life. The darker superimposed lesions typically appear and increase in number during childhood . Rarely, they may develop atypical nevi or malignant melanoma.


Fig. 20.12
A nevus spilus is characterized by a large tan patch with superimposed small dark macules
20.9.2 Histology
Most authors consider nevus spilus to be synonymous with speckled lentiginous nevus, and thus the histologic changes will be described as if they refer to the same entity [66, 67]. However, several recent publications have sought to make a distinction based upon subtle histologic differences, and these will be addressed [68, 69].
The major part of the surface of a nevus spilus is that of a flat, tan-colored macule that demonstrates the histologic features of a café au lait macule . The epidermis is remarkable for increased basilar melanin deposition with a slight increase in numbers of melanocytes, which are not enlarged and do not have cytologic atypia (Figs. 20.13, 20.14 and 20.15). The darker, also flat macules seen within these lesions demonstrate small nests of junctional melanocytes resembling a very small junctional melanocytic nevus. More papular lesions may show changes of a compound or intradermal melanocytic nevus. Rarely, these nevi are neurotized [70]. It has been proposed that nevus spilus that contains larger and more papular compound and intradermal melanocytic lesions is best categorized separately on the basis of different systemic associations [68].




Fig. 20.13
Nevus spilus is characterized by epidermal changes that resemble those seen in a lentigo simplex in some areas, and a junctional nevus in others. In some foci, a dermal melanocytic proliferation is present

Fig. 20.14
Foci indistinguishable from a compound nevus are present within nevus spilus

Fig. 20.15
Other areas of nevus spilus resemble lentigo simplex with slightly increased numbers of single melanocytes on elongated rete ridges within the epidermis
20.10 Nevus of Ito
20.10.1 Clinical Features
Nevus of Ito has a similar appearance and natural history to nevus of Ota (see Sect. 20.11), but it is located over the shoulder and supraclavicular area (Fig. 20.16). Nevus of Ito is common in Asian and black skin types, and more common in females than males [72].


Fig. 20.16
Nevus of Ito appears as a large blue patch over the arm and shoulder of a child
20.10.2 Histology
Histologic findings consist of a loose aggregation of densely pigmented, dendritic-shaped melanocytes within the superficial portion of the reticular dermis (Figs. 20.17 and 20.18). There is no intraepidermal melanocytic proliferation. Cytologic atypia and mitotic activity are not present, and the melanocytes tend to course as single cells and do not form nests. The histologic changes are indistinguishable from those of nevus of Ota, and the distinction is made based on the affected body site [73].



Fig. 20.17
Sparse numbers of densely pigmented spindled melanocytes are present in the superficial dermis in nevus of Ito. The epidermis is unremarkable

Fig. 20.18
Spindled melanocytes and melanophages course individually between reticular dermal collagen bundles in nevus of Ito
The histologic differential diagnosis includes a blue nevus. However, the dermal melanocytosis in a blue nevus is much more cellular and tightly aggregated than the diffuse and paucicellular collection in a nevus of Ito. Mongolian spots also share some histologic characteristics; however, these lesions are even less cellular with less apparent melanin pigment, and localized more deeply within the reticular dermis. In some cases, a tattoo might enter into the differential diagnosis. Stains for melanin or S100 to identify the melanocytic nature of the pigment-laden dendritic cells help make this distinction.
20.11 Nevus of Ota
20.11.1 Clinical Features
Nevus of Ota is most common in Asian and black skin types, and more common in females than males [72]. It is characterized by a unilateral patch of blue-gray to brown pigmentation on the face in the distribution of the ophthalmic and maxillary branches of the trigeminal nerve (Fig. 20.19). This corresponds to the temple, forehead, periorbital area, malar cheek, and nose. The ipsilateral eye is affected in 45–65 % of cases [75]. At least 50 % of the cases are congenital, and most lesions appear by puberty. They tend to be persistent and may darken after puberty. Although the lesions are usually benign, transformation to malignant melanoma has been reported.


Fig. 20.19
Nevus of Ota is a bluish-gray hyperpigmented patch on the side of the face in the distribution of trigeminal nerve innervation (photo courtesy of Minh Hoang, MD, Ho Chi Minh City, Vietnam)
20.11.2 Histology
Histologic findings consist of a loose aggregation of densely pigmented, dendritic-shaped melanocytes within the superficial portion of the reticular dermis (Figs. 20.20 and 20.21). The melanocytes tend to course singly and do not form nests. There is no intraepidermal melanocytic proliferation. Cytologic atypia and mitotic activity are not present. The changes are indistinguishable from those of nevus of Ito, and the distinction is made on the basis of the affected anatomic body site. An attempt to classify nevus of Ota into subtypes based upon the depth of the lesion has not been widely incorporated into diagnostic practice [76].



Fig. 20.20
Sparse numbers of densely pigmented and spindled melanocytes are present in the superficial dermis in nevus of Ota. The epidermis may be uninvolved or may demonstrate increased basilar melanin

Fig. 20.21
Spindled melanocytes and melanophages course individually between reticular dermal collagen bundles in nevus of Ota
The histologic differential diagnosis for nevus of Ota is similar to that described for nevus of Ito in Section 20.10.
20.11.3 Pathogenesis
Nevus of Ota can involve the periorbital skin, conjunctiva, neurovascular bundles, ganglia, and the uvea. The lesion may be due to aberrant migration of melanocytes from the neural crest to the dermal-epidermal junction, and subsequent arrest within the dermis [77]. Nevus of Ota generally does not change with age. However, the lesion may darken or enlarge in children during puberty and in postmenopausal women, indicating possible influence of sex hormones on dermal melanocytes.
Malignant transformation can occur in nevus of Ota, resulting in uveal, cutaneous, or dural melanoma [78, 79]. Genomic studies have identified mutations in the guanine nucleotide-binding protein G(q) subunit α (GNAQ) in nevus of Ota and uveal melanoma [80]. GNAQ is a subunit of the heterotrimeric G protein that mediates diverse receptor signal transduction pathways. The finding of GNAQ mutations in both nevus of Ota and uveal melanoma suggests a genetic link between these two lesions, and may provide the molecular basis for nevus of Ota being a risk factor for melanoma.
20.12 Congenital Melanocytic Nevus
20.12.1 Clinical Features
Congenital melanocytic nevi are melanocytic lesions that appear as pink/tan/brown to black macules and patches or papules and plaques (Figs. 20.22 and 20.23). Although typically present at birth, a subset of smaller nevi may appear later in the first year of life. Over time, they tend to thicken and often develop coarse terminal hairs. They are classified by size as small (<1.5 cm), medium (1.5–19.9 cm), and large (≥20 cm). Some classify “giant” lesions as ≥40 cm. Large and “giant” lesions, in particular, carry a significant risk of malignant melanoma, and may also be associated with neurocutaneous melanosis (pigmented lesions in the brain and spinal cord).



Fig. 20.22
Small congenital melanocytic nevus appears as a well-defined brown patch present at birth

Fig. 20.23
Giant congenital melanocytic nevus is a large thin brown plaque with multiple darker-brown macules and papules within it as well as coarse terminal hairs over the surface
Small congenital melanocytic nevus occurs in approximately 1 % of all newborns [81]. Large lesions are less common, occurring in approximately 1:20,000 newborns [82]. Larger lesions tend to occur on the trunk, especially over the back and buttocks, and they are often accompanied by multiple scattered smaller pigmented lesions (satellite nevi).
20.12.2 Histology
There are no histologic features that reliably serve to distinguish a congenital melanocytic nevus from an acquired melanocytic nevus. Both congenital and acquired nevi can be identified with involvement of solely the epidermis (junctional) and solely the dermis (intradermal), or involvement of both the epidermis and dermis (compound) [83].
Junctional melanocytic nevi demonstrate nests of melanocytes along the dermal-epidermal junction, with the majority of nests located at the base of the rete ridges. In children, the nests tend to be larger than those seen in adults. Similarly, the intraepidermal melanocytes themselves tend to be somewhat larger and contain more cytoplasm. Single melanocytes are frequently encountered along the basal layer, and scattered pagetoid cells are not infrequent, especially in the central portion of the lesion. These features, while concerning in acquired nevi within adults, are an expected finding in congenital nevi, and they are more prominent in lesions biopsied in infants. Care should be taken to not interpret these findings as those seen within a superficial spreading melanoma, and to not make the diagnosis of melanoma in this population.
Compound congenital melanocytic nevi demonstrate similar intraepidermal melanocytic components but, in addition, there are collections of melanocytes within the dermis. There are several features that are more commonly seen in congenital nevi than in acquired ones, although none of these is pathognomonic. Congenital-pattern nevi tend to extend deep into the lower two thirds of the reticular dermis, a feature not usually associated with acquired nevi (Figs. 20.24, 20.25 and 20.26). There is characteristic growth around and extension down cutaneous appendages in congenital nevi . Sheets of benign-appearing melanocytes may replace the typical melanocytic nesting pattern . There is maturation of the melanocytes with progressive descent into the dermis, which is analogous to that seen in acquired nevi. Unlike most acquired melanocytic nevi, rare mitoses may be seen within the dermal component of congenital nevi, but mitoses should not occur near the base of the lesion [84].




Fig. 20.24
A congenital nevus demonstrates pigmented melanocytic nesting in the superficial portion of the dermis, while deeper down the cells form a sheet-like growth pattern and lose much of their pigment

Fig. 20.25
Congenital nevi extend deep into the reticular dermis and may grow around cutaneous appendages and infiltrate arrector pili muscles . The cells develop a neuroid appearance in the deep portion

Fig. 20.26
Melanocytes are seen intimately associated with cutaneous appendages in congenital nevi
In rare cases, one may encounter nodules of melanocytes in which there is an apparent lack of maturation, and the cells appear remarkably clonal (Figs. 20.27 and 20.28). These are proliferative nodules , and require more careful histologic examination. In general, these are areas that at low magnification demonstrate increased cellular density and lack of maturation as well as increased mitotic activity, but no atypical mitoses [85] (Fig. 20.29). Necrosis is also not a feature of benign proliferative nodules, and in many cases, there is a smooth transition from the surrounding dermal nevus components to the proliferative nodule [86] (Fig. 20.28). Some authors have suggested that the absence of destructive expansile growth is another feature that distinguishes a benign proliferative nodule from melanoma [87].




Fig. 20.27
A proliferative nodule is easily observed at low magnification as a clearly demarcated nodule of melanocytes with increased cellularity and lack of maturation

Fig. 20.28
Proliferative nodules are clearly demarcated from the surrounding dermal melanocytes

Fig. 20.29
The melanocytes within a proliferative nodule have vesicular nuclei, scattered nucleoli, and increased mitotic activity
Intradermal congenital melanocytic nevi demonstrate similar histologic features within the dermis to those seen in compound nevi. Nests of epidermal melanocytes are absent in purely intradermal nevi. Additional features, such as neurotization of the melanocytes, may also be seen, especially in older lesions [85].
The histologic differential diagnosis includes melanoma and dysplastic nevus. Melanomas, while rare in children, certainly do occur, and with increased frequency in association with large congenital melanocytic nevi. Melanomas may arise within the epidermis, and in such cases resemble melanomas that occur in adults. These are characterized by increased numbers of single melanocytes present at all levels of the epidermis, and display marked cytologic atypia. Melanomas can also occur in association with proliferative nodules. In these situations, the presence of marked cytologic atypia, nuclear pleomorphism, increased cellular density, increased mitoses including atypical forms, clear demarcation from surrounding populations of benign-appearing melanocytes, and necrosis all point toward the diagnosis of melanoma.
There are situations in which the changes along the dermal-epidermal junction seen in a congenital nevus are quite similar to those that have been described in dysplastic nevi . The presence of nests of melanocytes between the rete ridges, basilar lentiginous melanocytic hyperplasia, fibrosis, and a lymphocytic inflammatory response are commonly encountered in congenital nevi. The melanocytes themselves may be enlarged depending on the age of the patient , further enhancing the histologic similarity. However, dysplastic nevi do not ordinarily extend into the reticular dermis, which is a feature seen in virtually all congenital nevi, and this may help in making the histologic distinction.
20.12.3 Pathogenesis
Congenital melanocytic nevi present at birth frequently harbor NRAS mutations. In a study of 32 congenital nevi, 81 % of the lesions had NRAS mutations with 70 % of proliferative nodules that developed within the congenital nevi also having mutations in NRAS [88]. No mutations in BRAF were found in this study. Interestingly, melanocytic nevi with a “congenital pattern,” but no clear history of the nevus being present since birth (i.e., truly congenital), harbor BRAF V600E mutation [89–91]. It has been suggested that the discrepancies in these reports may be due to differences in the classification of nevus as congenital based upon histologic criteria and not on the actual presence of the nevus at birth [88]. Congenital nevi that develop in utero appear to be genetically distinct from acquired nevi that develop later in life.
The development of melanocytes in utero is regulated by c-Met (MET proto-oncogene, receptor tyrosine kinase) and c-Kit (V-Kit Hardy-Zuckerman 4 feline sarcoma viral oncogene homologue) [92, 93]. c-Met encodes a receptor tyrosine kinase that binds hepatocyte growth factor (HGF) . Overexpression of HGF and c-Met receptor activation are associated with disorders of differentiation, proliferation, and migration of melanocytes, and could be related to the occurrence of congenital nevi [94, 95]. c-Kit gene encodes a receptor tyrosine kinase that binds to stem cell factor (SCF) , which is important in the development of melanocytes [96]. Increased c-Kit expression is seen in proliferative nodules in congenital nevi [97]. Given their known roles in melanocyte development, c-Met and c-Kit may play important roles in the development of congenital nevi.
20.13 Spitz Nevus
20.13.1 Clinical Features
Spitz nevus (spindle and epithelioid cell nevus) is a subtype of melanocytic nevi seen primarily in children. In the past, it was known as “benign juvenile melanoma ” due to histologic features similar to those seen in malignant melanoma. It usually appears as a red to brown dome-shaped papule or nodule, often located on the face of a child or adolescent (Fig. 20.30). Most range in size from a few millimeters up to one centimeter in diameter . On occasion, the pigment is quite dark brown to black. Although most Spitz nevi are benign, they can have a range of histologically atypical features and can show aggressive behavior at times.


Fig. 20.30
Spitz nevus may appear as a small reddish-brown papule as seen on the cheek of this child
The true incidence and prevalence of Spitz nevi are unknown. It has been estimated that they account for approximately 1 % of all surgically-excised melanocytic lesions [98]. Spitz nevi are most common in the pediatric age group. In one series, 70 % were seen in individuals under 20 years of age, and 50 % were seen in children under 10 years of age [98].
20.13.2 Histology
Spitz nevus demonstrates histologic changes that are usually quite distinctive [99]. As with other melanocytic nevi, Spitz nevi can be seen in the junctional, compound, or purely intradermal stages of evolution.
The most commonly encountered stage of development, and the most classic histologic changes are seen in compound Spitz nevus. In this lesion, a well-circumscribed proliferation of melanocytes is present within the epidermis (Fig. 20.31). The nests tend to be quite large and, in most cases, the melanocytes demonstrate a vertical orientation (Fig. 20.32). A characteristic finding is the presence of clefts separating the overlying keratinocytes from the large intraepidermal melanocytic nests. Scattered single melanocytes, including pagetoid cells, are present throughout the epidermis, but the pagetoid extension is usually confined to the central portion of the lesion. Epidermal hyperplasia is a common feature in Spitz nevi. Epidermal changes, in which the epidermis is focally atrophic and large nests of junctional melanocytes occupy the majority of the epidermis, have also been described [100]. Eosinophilic globules, known as Kamino bodies , are present at the base of the epidermis or in the papillary dermis in many cases, but these globules are not entirely specific for Spitz nevi.



Fig. 20.31
A Spitz nevus is characterized by a sharply-circumscribed proliferation of large nests of intraepidermal and dermal melanocytes with abundant cytoplasm

Fig. 20.32
Spitz nevus cells have characteristic morphology with abundant cytoplasm, vesicular nuclei, and conspicuous nucleoli. Pagetoid cells are sometimes present
In compound Spitz nevus, nests of melanocytes displaying similar morphologic features are present in the dermis as well as in the epidermis. The cells are characteristically quite large with abundant eosinophilic cytoplasm, vesicular nuclei, and prominent nucleoli. They may be purely epithelioid, purely spindled, or an admixture of shapes. As is the case with other benign melanocytic proliferations, there is cellular maturation with progressive descent into the dermis. Melanocytes become smaller, and the nests of cells diminish in size and are separated by increasing amounts of dermal collagen. In marked distinction from ordinary acquired nevi and congenital nevi, rare dermal mitoses are an expected finding in Spitz nevi. However, the mitoses should not be atypical, and they should be present in the upper portions of the dermis [101]. In some cases, a lymphocytic immune response is present [102]. Lymphatic invasion has been identified in up to 15 % of ordinary Spitz nevi, and should not prompt a diagnosis of melanoma [103].
A purely dermal Spitz nevus demonstrates identical changes within the dermis to that described in compound Spitz nevus with the exception that the intraepidermal component is not present (Figs. 20.33, 20.34 and 20.35). Some dermal Spitz nevi have abundant dermal sclerosis separating the dermal melanocytes .




Fig. 20.33
A dermal Spitz nevus lacks an epidermal component of melanocytic proliferation . The dermis is filled with large cells that have abundant cytoplasm

Fig. 20.34
Spindled and epithelioid cells with abundant cytoplasm, characteristic of Spitz nevi, fill the dermis which is often separated by sclerotic collagen
Fig. 20.35
The melanocytes within a dermal Spitz nevus have abundant cytoplasm, vesicular nuclei, and prominent nucleoli, and are indistinguishable from the cells that comprise a compound Spitz nevus
A purely junctional Spitz nevus has been described. It is the least commonly biopsied variant of Spitz nevi. In a junctional Spitz nevus, the melanocytic proliferation is confined to within the epidermis, and is identical to the epidermal component described for a compound Spitz nevus (Fig. 20.36). The lesion may demonstrate many pagetoid cells, but it should be small, relatively circumscribed , and symmetrical with an even distribution of melanocytic nests and no significant cytologic atypia (Fig. 20.37) [104].



Fig. 20.36
A junctional Spitz nevus displays all of the histologic features of a compound Spitz nevus without a dermal component. There are large nests of melanocytes with characteristic cytomorphology

Fig. 20.37
Spitz nevus cells are spindled and epithelioid with abundant eosinophilic cytoplasm, vesicular nuclei, and occasionally visible nucleoli
In most cases, it is relatively straightforward to distinguish a Spitz nevus from a Spitzoid melanoma. Key distinguishing features of melanoma include a higher degree of pagetoid spread, greater cellular density, nuclear pleomorphism and hyperchromasia, and increased mitotic activity [105, 106]. Mitoses near the base of the lesion and atypical mitoses are further indicators of malignancy [107]. However, there are some instances where this distinction is not simple. For these cases, the term “atypical Spitzoid tumor ” has been proposed (Figs. 20.38, 20.39, 20.40, 20.41, and 20.42). Features that should prompt this diagnosis include Spitzoid cellular morphology with age greater than 10 years, diameter greater than 10 mm, ulceration, involvement of the subcutaneous fat, and greater than six mitoses per mm2 [108]. Lack of complete cellular maturation with progressive dermal descent should also raise the possibility of an atypical lesion. Fluorescence in situ hybridization (FISH) testing has been useful in distinguishing between Spitz nevus and Spitzoid melanoma, although this technique may be more reliable in adults than in children [109]. Atypical Spitzoid lesions appear to have minimal malignant potential in children [110]. In some cases, sentinel lymph node biopsies have demonstrated the presence of atypical Spitz nevus (or Spitzoid melanoma) cells in the lymph nodes. The prognosis in these cases appears to be excellent, but the series of cases is small [111, 112].






Fig. 20.38
Atypical Spitz nevus is a sharply-circumscribed lesion composed of spindled and epithelioid melanocytes that are nested but have a slightly increased nuclear to cytoplasmic ratio

Fig. 20.39
Epidermal hyperplasia and large nests of cells are present within the epidermis of an atypical Spitz nevus

Fig. 20.40
Characteristic Spitzoid morphology with clefting over the nests is seen in the epidermis of an atypical Spitz nevus
Fig. 20.41
The dermal component of an atypical Spitz nevus demonstrates cells with characteristic Spitzoid morphology of abundant eosinophilic cytoplasm, vesicular nuclei, and visible nucleoli. Cellularity is higher than in a common Spitz nevus

Fig. 20.42
The deepest component of an atypical Spitz nevus shows melanocytes with incomplete maturation and increased cellularity
20.13.3 Pathogenesis
Spitz nevus is known to carry mutations and copy number increase in the HRAS gene [113]. Since HRAS mutations are found in Spitz nevus, but not in Spitzoid melanoma, HRAS may be used as a diagnostic test to help differentiate between these two lesions [114, 115]. Analysis for BRAF mutations has not shown mutations in Spitz nevus in most reported studies [116–118]. However, a few studies have reported mutations in BRAF in a subset of Spitz nevi, some of which have atypical histologic features [119, 120]. RAS is an upstream activator of the MAP-kinase pathway, and consistent with this, Spitz nevus has high levels of phosphorylated ERK, which is a component in this pathway [121]. Spitz nevus also has high levels of p16 INK4a (CDKN2A), which is a cell-cycle inhibitory protein and a tumor suppressor [122, 123].
20.14 Pigmented Spindle Cell Nevus (Reed Nevus)
20.14.1 Clinical Features
Pigmented spindle cell nevus is considered to be a more heavily pigmented variant of Spitz nevus, although this has been somewhat controversial [124]. It is most common in young adults, although it does occasionally occur in children (Fig. 20.43). The nevus tends to appear as a dark brown to black macule or papule measuring 3–5 mm, often on the lower extremity (particularly the thigh) of a young woman.


Fig. 20.43
Pigmented spindle cell nevus appears as a dark brown to black papule with irregular borders
20.14.2 Histology
Pigmented spindle cell nevus is characterized by a symmetrical, sharply circumscribed proliferation of nested and densely pigmented spindle-shaped melanocytes located along the dermal-epidermal junction (Figs. 20.44, 20.45 and 20.46). The nests of melanocytes tend to be large, and have a vertical orientation similar to those seen in a Spitz nevus [127, 128]. The nests may be confined solely in the epidermis, or extend into the dermis with similar morphologic features . Scattered pagetoid cells are present in the central portion of the lesion, but they should not occur at the periphery. The melanocytes display striking uniformity in appearance, and cytologic atypia is not a feature of these lesions. Eosinophilic globules (Kamino bodies) are seen in up to 50 % of cases, and clefting between keratinocytes and epidermal nests of melanocytes is frequently present. Rare mitoses may be seen, but they should not be atypical or present at the base of the lesion. As with other benign nevi, maturation of nevus cells should be present with progressive descent into the dermis. While the melanocytes are predominantly spindle-shaped, epithelioid melanocytes may be admixed, resulting in histologic overlap with ordinary Spitz nevi. Up to 7 % of cases can have some histologic features of a dysplastic nevus [129]. An underlying lymphocytic immune response is seen in many pigmented spindle cell nevi.






